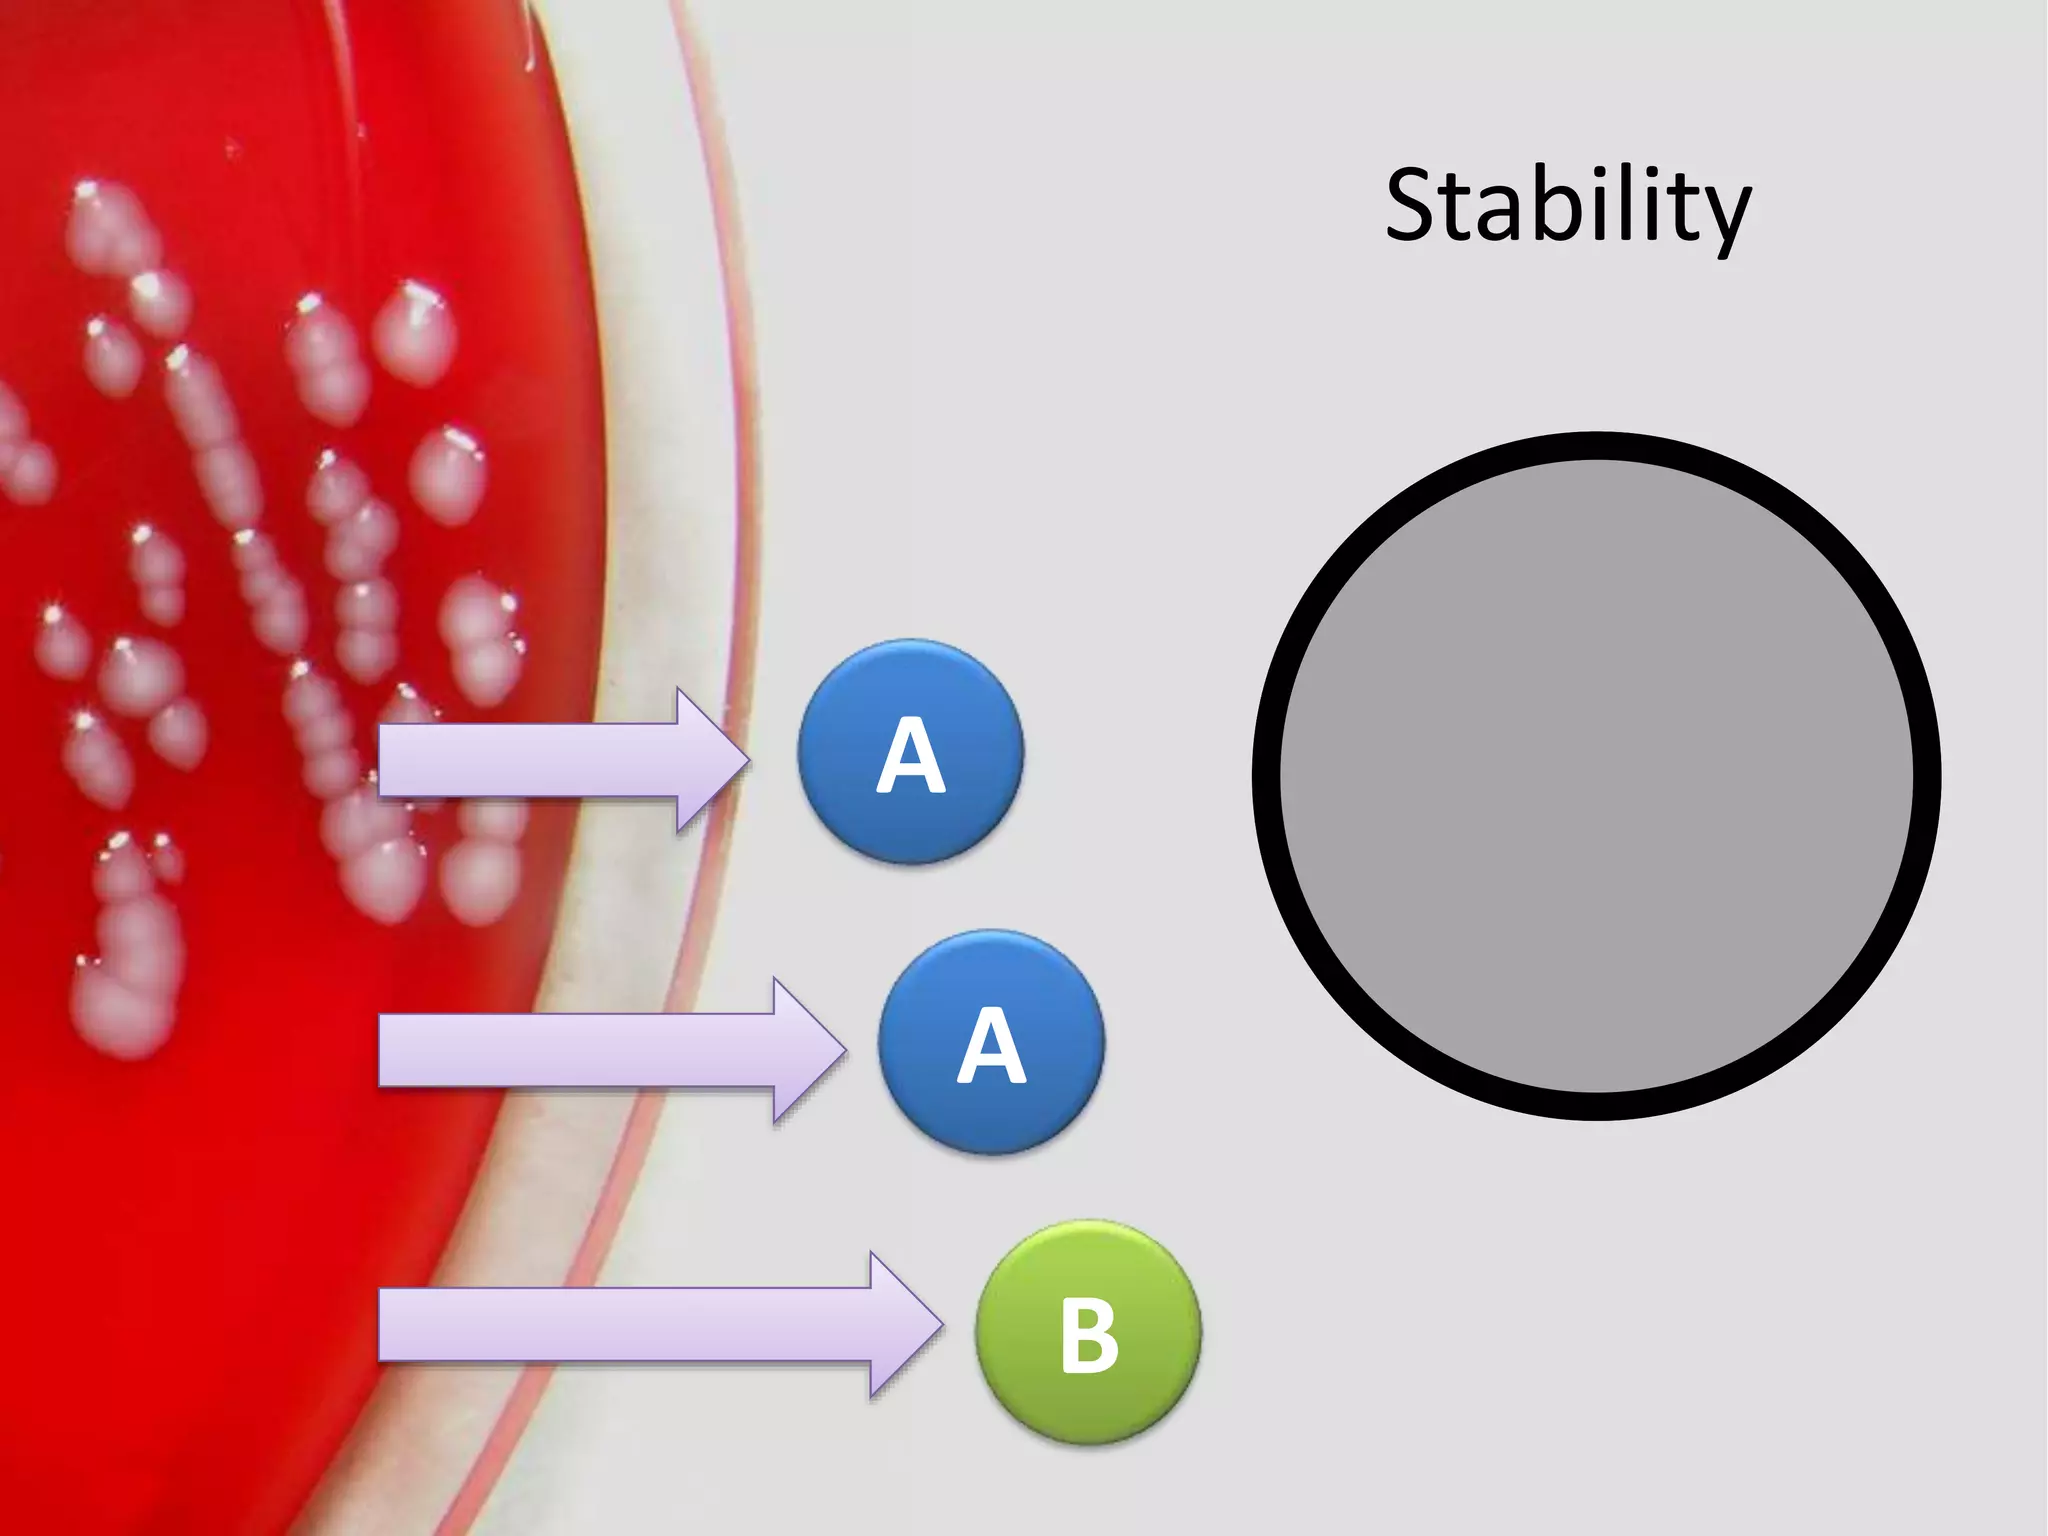
A
A
B
Stability
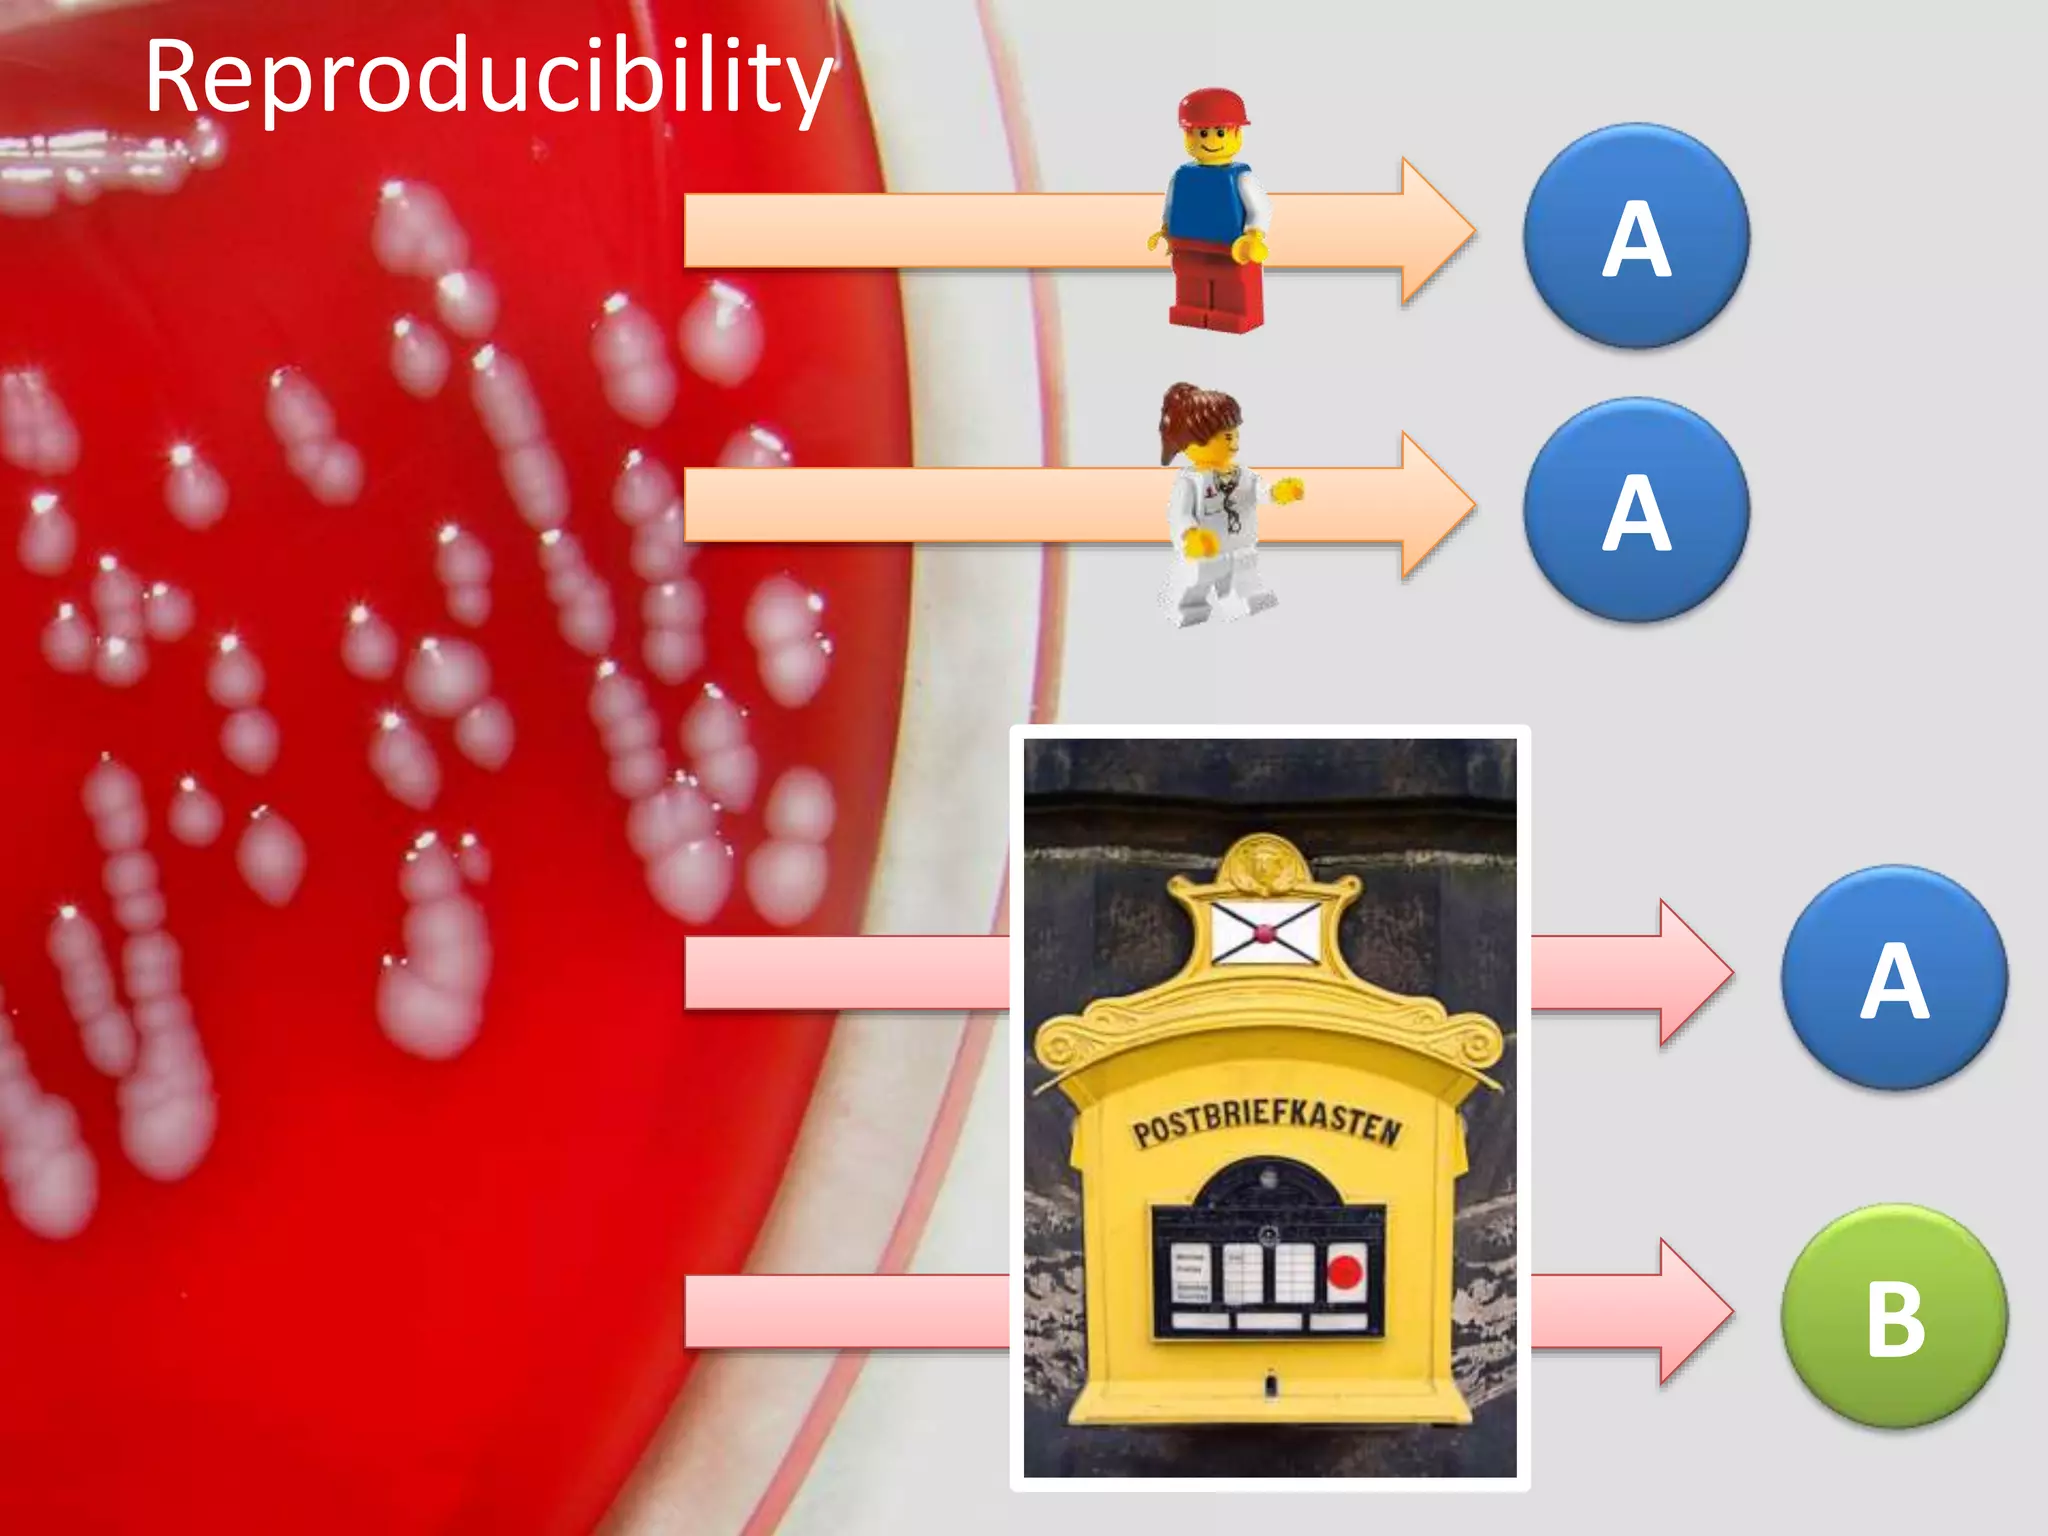
A
A
Reproducibility
B
A

The document evaluates various molecular typing techniques for bacterial isolates, focusing on their discriminatory power and suitability for outbreak investigations and epidemiological studies. It compares methods like PFGE, MLST, and others, highlighting PFGE as the most discriminatory, while FLAB offers rapid and reproducible results. The paper also provides statistical assessments and examples of typing concordance in Campylobacter outbreaks.

![Typing:
Phenotypic and/or genetic
analysis of bacterial isolates,
below the species/subspecies
level, performed in order to
generate strain/clone-specific
fingerprints […]
van Belkum et al., (2007). CMI, 13:1](https://image.slidesharecdn.com/typingsystemevaluation-140820033811-phpapp01/75/Evaluation-of-Moleculare-Typing-Techniques-2-2048.jpg)

![A
B
C
D
E
E
Typing method 1
a
b
c
c
b
b
Typing method 2
DI: 0.933 [0.805 – 1.0] DI: 0.733 [0.53 – 0.936]
Discriminatory
power](https://image.slidesharecdn.com/typingsystemevaluation-140820033811-phpapp01/75/Evaluation-of-Moleculare-Typing-Techniques-10-2048.jpg)















